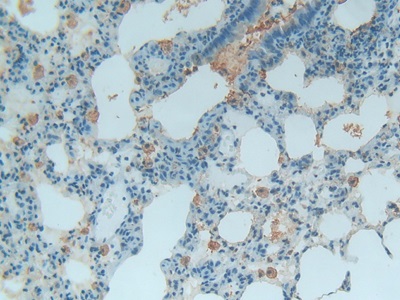
https://d1vffmuvmgkypt.cloudfront.net/image/ridacom_ltd/cloud_clone_corp/PRODUCT_SOURCE__CLOUD_CLONE__SUPPLIER__RIDACOM__ID__PAA702Ra01__5

Antigen
TXN
Isotype
IgG
(4)
IgG2a
(1)
Reactivity
Human
(11)
Mouse
(9)
Rat
(9)
Spinach
(1)
Research area
Developmental science
(13)
Metabolic pathway
(13)
Clonality
Polyclonal
(7)
Monoclonal
(1)
Application
Western Blotting
(17)
Immunocytochemistry
(10)
Immunohistochemistry
(10)
ELISA
(4)
Enzyme-linked immunosorbent assay for Antigen Detection
(4)
Immunoprecipitation
(4)
Immunofluorescence
(3)
Positive Control
(3)
SDS-PAGE
(3)
Chemiluminescent immunoassay for antigen detection
(1)
Supplier
Cloud-Clone Corp.
(18)
Affinity Biosciences
(3)
Abbkine Scientific Co., Ltd.
(2)
Test method
Double-antibody Sandwich
(5)
Colorimetric
(1)
Host
Rabbit
(7)
293F
(3)
CHO
(3)
Mouse
(1)
Category
Antibodies
(14)
ELISA Kits
(6)
Cell biology
(3)
Immunochemicals
(3)
Protein Biochemistry
(3)
| 48T | $630.00 | |
| 96T | $900.00 | |
| 96T*5 | $4,050.00 |
| 96T*10 | $7,650.00 | |
| 96T*100 | $63,000.00 |
| 48T | $588.00 | |
| 96T | $840.00 | |
| 96T*5 | $3,780.00 |
| 96T*10 | $7,140.00 | |
| 96T*100 | $58,800.00 |
| 48T | $479.00 | |
| 96T | $684.00 | |
| 96T*5 | $3,078.00 |
| 96T*10 | $5,814.00 | |
| 96T*100 | $47,880.00 |
| 48T | $454.00 | |
| 96T | $648.00 | |
| 96T*5 | $2,916.00 |
| 96T*10 | $5,508.00 | |
| 96T*100 | $45,360.00 |
| 48T | $441.00 | |
| 96T | $630.00 | |
| 96T*5 | $2,835.00 |
| 96T*10 | $5,355.00 | |
| 96T*100 | $44,100.00 |

Antigen:
Thioredoxin
Synonyms: TXN; ADF; SASP; TRDX; TRX1; ATL-derived factor; Surface-associated sulphydryl protein
Reactivity:Mouse
Application:Positive Control; SDS-PAGE; Western Blotting
Research area:Metabolic pathway; Developmental science
Preparation method:Escherichia coli
| 10µg | $168.00 | |
| 50µg | $420.00 | |
| 200µg | $840.00 |
| 1mg | $2,520.00 | |
| 5mg | $6,300.00 |

Antigen:
Thioredoxin
Synonyms: TXN; ADF; SASP; TRDX; TRX1; ATL-derived factor; Surface-associated sulphydryl protein
Reactivity:Rat
Application:Positive Control; SDS-PAGE; Western Blotting
Research area:Metabolic pathway; Developmental science
Preparation method:Escherichia coli
| 10µg | $168.00 | |
| 50µg | $420.00 | |
| 200µg | $840.00 |
| 1mg | $2,520.00 | |
| 5mg | $6,300.00 |

Antigen:
Thioredoxin
Synonyms: TXN; ADF; SASP; TRDX; TRX1; ATL-derived factor; Surface-associated sulphydryl protein
Reactivity:Human
Application:Positive Control; SDS-PAGE; Western Blotting
Research area:Metabolic pathway; Developmental science
Preparation method:Escherichia coli
| 10µg | $156.00 | |
| 50µg | $390.00 | |
| 200µg | $780.00 |
| 1mg | $2,340.00 | |
| 5mg | $5,850.00 |

Antigen:
Thioredoxin
Synonyms: TXN; ADF; SASP; TRDX; TRX1; ATL-derived factor; Surface-associated sulphydryl protein
Host:293F
Reactivity:Rat
Application:Western Blotting; Immunohistochemistry; Immunocytochemistry; Immunofluorescence
Research area:Metabolic pathway; Developmental science
| 20µl | $123.00 | |
| 100µl | $287.00 | |
| 200µl | $410.00 |
| 1ml | $1,025.00 | |
| 10ml | $4,100.00 |
TXN Antibody
$280.00

Antigen:
Thioredoxin
Synonyms: ATL-derived factor; Surface-associated sulphydryl protein; THIO_HUMAN; B1ALW1; O60744; P10599; Q53X69; Q96KI3; Q9UDG5
Host:Rabbit
Reactivity:Human; Mouse; Rat
Application:Western Blotting; ELISA
Isotype:IgG
Clonality:Polyclonal
Aliases:ADF; ATL derived factor; ATL-derived factor; DKFZp686B1993; MGC61975; SASP; Surface associated sulphydryl protein; Surface-associated sulphydryl protein; testicular tissue protein Li 199; THIO_HUMAN; Thioredoxin; thioredoxin delta 3; TRDX; TRX 1; Trx; TRX1; TXN; TXN delta 3; TXN protein; zgc:92903

Antigen:
Thioredoxin
Synonyms: ATL-derived factor; Surface-associated sulphydryl protein; THIO_HUMAN; B1ALW1; O60744; P10599; Q53X69; Q96KI3; Q9UDG5
Test method:Colorimetric
Thioredoxins are proteins that act as antioxidants by facilitating the reduction of other proteins by cysteine thiol-disulfide exchange. Thioredoxins are found in nearly all known organisms and are essential for life in mammals.Thioredoxins are characterized at the level of their amino acid sequence by the presence of two vicinal cysteines in a CXXC motif. These two cysteines are the key to the ability of thioredoxin to reduce other proteins. Thioredoxin proteins also have a characteristic tertiary structure termed the thioredoxin fold.The thioredoxins are kept in the reduced state by the flavoenzyme thioredoxin reductase, in a NADPH-dependent reaction. Thioredoxins act as electron donors to peroxidases and ribonucleotide reductase.
| 48T | $280.00 | |
| 96T | $480.00 |
| 96T*5 | $2,160.00 | |
| 96T*50 | $20,160.00 |

Antigen:
Thioredoxin
Synonyms: TXN; ADF; SASP; TRDX; TRX1; ATL-derived factor; Surface-associated sulphydryl protein
Host:293F
Reactivity:Mouse
Application:Western Blotting; Immunohistochemistry; Immunocytochemistry; Immunofluorescence
Research area:Metabolic pathway; Developmental science
| 20µl | $116.00 | |
| 100µl | $272.00 | |
| 200µl | $388.00 |
| 1ml | $970.00 | |
| 10ml | $3,880.00 |

Antigen:
Thioredoxin
Synonyms: TXN; ADF; SASP; TRDX; TRX1; ATL-derived factor; Surface-associated sulphydryl protein
Host:293F
Reactivity:Human
Application:Western Blotting; Immunohistochemistry; Immunocytochemistry; Immunofluorescence
Research area:Metabolic pathway; Developmental science
| 20µl | $113.00 | |
| 100µl | $265.00 | |
| 200µl | $378.00 |
| 1ml | $945.00 | |
| 10ml | $3,780.00 |

Antigen:
Thioredoxin
Synonyms: TXN; ADF; SASP; TRDX; TRX1; ATL-derived factor; Surface-associated sulphydryl protein
Host:CHO
Reactivity:Rat
Application:Western Blotting; Immunohistochemistry; Immunocytochemistry
Research area:Metabolic pathway; Developmental science
| 20µl | $113.00 | |
| 100µl | $263.00 | |
| 200µl | $376.00 |
| 1ml | $940.00 | |
| 10ml | $3,760.00 |
Phospho-TXN(Thr100) Antibody
$250.00

Antigen:
Thioredoxin
Synonyms: ATL-derived factor; Surface-associated sulphydryl protein; THIO_HUMAN; B1ALW1; O60744; P10599; Q53X69; Q96KI3; Q9UDG5
Host:Rabbit
Reactivity:Human; Mouse; Rat
Application:Western Blotting; ELISA
Isotype:IgG
Clonality:Polyclonal
Aliases:ADF; ATL derived factor; ATL-derived factor; DKFZp686B1993; MGC61975; SASP; Surface associated sulphydryl protein; Surface-associated sulphydryl protein; testicular tissue protein Li 199; THIO_HUMAN; Thioredoxin; thioredoxin delta 3; TRDX; TRX 1; Trx; TRX1; TXN; TXN delta 3; TXN protein; zgc:92903
TXN Antibody
$250.00

Antigen:
Thioredoxin
Synonyms: ATL-derived factor; Surface-associated sulphydryl protein; THIO_HUMAN; B1ALW1; O60744; P10599; Q53X69; Q96KI3; Q9UDG5
Host:Rabbit
Reactivity:Human; Mouse; Rat
Application:Western Blotting; ELISA
Isotype:IgG
Clonality:Polyclonal
Aliases:ADF; ATL derived factor; ATL-derived factor; DKFZp686B1993; MGC61975; SASP; Surface associated sulphydryl protein; Surface-associated sulphydryl protein; testicular tissue protein Li 199; THIO_HUMAN; Thioredoxin; thioredoxin delta 3; TRDX; TRX 1; Trx; TRX1; TXN; TXN delta 3; TXN protein; zgc:92903
| 50μl | $250.00 | |
| 100μl | $350.00 |
| 200μl | $450.00 |

Antigen:
Thioredoxin
Synonyms: TXN; ADF; SASP; TRDX; TRX1; ATL-derived factor; Surface-associated sulphydryl protein
Host:CHO
Reactivity:Mouse
Application:Western Blotting; Immunohistochemistry; Immunocytochemistry
Research area:Metabolic pathway; Developmental science
| 20µl | $107.00 | |
| 100µl | $249.00 | |
| 200µl | $356.00 |
| 1ml | $890.00 | |
| 10ml | $3,560.00 |

Antigen:
Thioredoxin
Synonyms: TXN; ADF; SASP; TRDX; TRX1; ATL-derived factor; Surface-associated sulphydryl protein
Host:CHO
Reactivity:Human
Application:Western Blotting; Immunohistochemistry; Immunocytochemistry
Research area:Metabolic pathway; Developmental science
| 20µl | $104.00 | |
| 100µl | $242.00 | |
| 200µl | $346.00 |
| 1ml | $865.00 | |
| 10ml | $3,460.00 |

Antigen:
Thioredoxin
Synonyms: TXN; ADF; SASP; TRDX; TRX1; ATL-derived factor; Surface-associated sulphydryl protein
Host:Rabbit
Reactivity:Rat
Application:Western Blotting; Immunohistochemistry; Immunocytochemistry; Immunoprecipitation
Clonality:Polyclonal
Research area:Metabolic pathway; Developmental science
| 20µl | $103.00 | |
| 100µl | $239.00 | |
| 200µl | $342.00 |
| 1ml | $855.00 | |
| 10ml | $3,420.00 |

Antigen:
Thioredoxin
Synonyms: TXN; ADF; SASP; TRDX; TRX1; ATL-derived factor; Surface-associated sulphydryl protein
Host:Mouse
Reactivity:Human
Application:Western Blotting; Immunohistochemistry; Immunocytochemistry; Immunoprecipitation
Isotype:IgG2a
Clonality:Monoclonal
Research area:Metabolic pathway; Developmental science
| 20µl | $101.00 | |
| 100µl | $235.00 | |
| 200µl | $336.00 |
| 1ml | $840.00 | |
| 10ml | $3,360.00 |

Antigen:
Thioredoxin
Synonyms: TXN; ADF; SASP; TRDX; TRX1; ATL-derived factor; Surface-associated sulphydryl protein
Host:Rabbit
Reactivity:Mouse
Application:Western Blotting; Immunohistochemistry; Immunocytochemistry; Immunoprecipitation
Clonality:Polyclonal
Research area:Metabolic pathway; Developmental science
| 20µl | $97.00 | |
| 100µl | $227.00 | |
| 200µl | $324.00 |
| 1ml | $810.00 | |
| 10ml | $3,240.00 |

Antigen:
Thioredoxin
Synonyms: TXN; ADF; SASP; TRDX; TRX1; ATL-derived factor; Surface-associated sulphydryl protein
Host:Rabbit
Reactivity:Human
Application:Western Blotting; Immunohistochemistry; Immunocytochemistry; Immunoprecipitation
Clonality:Polyclonal
Research area:Metabolic pathway; Developmental science
| 20µl | $95.00 | |
| 100µl | $221.00 | |
| 200µl | $316.00 |
| 1ml | $790.00 | |
| 10ml | $3,160.00 |

Antigen:
Thioredoxin
Synonyms: ATL-derived factor; Surface-associated sulphydryl protein; THIO_HUMAN; B1ALW1; O60744; P10599; Q53X69; Q96KI3; Q9UDG5
Host:Rabbit
Reactivity:Human; Mouse; Rat
Application:Western Blotting; ELISA
Isotype:IgG
Clonality:Polyclonal








-SCA702Hu-000001.png)



-SEA702Ra-000001.png)



-SEA702Mu-000001.png)



-SEA702Hu-000001.png)

-RPA702Mu01-000001.png)



-RPA702Hu01-000001.png)












-LAA702Hu71-000001.png)

-MAA702Hu22-000001.png)



-PAA702Mu01-000001.png)



-PAA702Hu01-000001.png)
